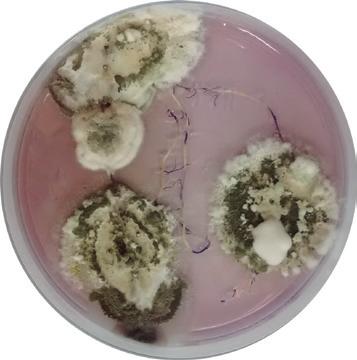

9 minute read
Fungos promotores de crescimento
from Cultivar HF 127
Agentes multifuncionais
Populares por seu efeito como pesticida biológico os fungos entomopatogênicos do gênero Metarhizium ganham espaço também como estimuladores de crescimento vegetal e inibidores de fitopatógenos nas plantas
Os fungos entomopatogênicos são micro-organismos amplamente utilizados no controle biológico de pragas agrícolas. Conhecidos como biopesticidas, pesticidas microbianos ou somente “biológicos”, estes agentes possuem ocorrência natural nos mais diversos habitats, incluindo o solo, grande reservatório de espécies microbianas e que possibilita a sobrevivência destes organismos na ausência de seus hospedeiros. Os fungos foram os primeiros micro-organismos a serem utilizados no controle de insetos e atualmente são os patógenos mais utilizados no Controle Biológico Aplicado, que é aquele onde há a liberação de um agente biológico de forma “inundativa” no agroecossistema, para a rápida redução da praga no ambiente.
O modo de ação destes micro-organismos se dá pelo contato
Horticeres
Fotos Alice Nagata
Colonização endofítica dos tecidos


Controle M. robertsii M. humberi
Potencial quanto ao crescimento das plântulas foi analisado
do conídio, também chamado de “esporo”, no corpo do inseto. Sob condições ideais de temperatura e umidade, o fungo germina e penetra no inseto, por meio da produção de enzimas. Dentro do inseto, estes fungos passam a se multiplicar nos tecidos, e algumas espécies podem produzir também toxinas que levam a morte da praga. Por fim, o fungo sai de seu hospedeiro, produzindo mais esporos que se dispersarão no ambiente. Inúmeras espécies de fungos entomopatogênicos são comercializadas no Brasil e no restante do mundo para o controle biológico das mais diversas espécies de insetos-praga, de diferentes culturas agrícolas. No Brasil é possível destacar a ampla utilização do fungo Metarhizium anisopliae, no biocontrole da cigarrinha-das-raízes, Mahanarva fimbriolata, em cana-de-açúcar e também Deois flavopicta em pastagens, sendo este um dos programas de maior sucesso de controle biológico no País. Atualmente, Metarhizium anisopliae é ingrediente ativo de 58 bioprodutos e estima-se que sua aplicação ultrapasse dois milhões de hectares por ano, sendo crescente a adesão por parte dos produtores e aumento no número de empresas nacionais e estrangeiras que têm buscado incluir este agente de controle biológico em seus portfólios.
Fungos do gênero Metarhizium podem infectar e matar uma ampla gama de ordens de insetos, desde sugadores até os mastigadores. Algumas espécies são específicas para determinados grupos de insetos, enquanto a maioria é generalista na escolha de seus hospedeiros, o que colabora com o sucesso no emprego deste agente no manejo de diversos insetos-praga. Até então, os fungos entomopatogênicos do gênero Metarhizium eram utilizados apenas para o controle de pragas e, até há alguns anos, pouco se sabia sobre sua ecologia e distribuição de suas espécies em ambientes naturais e agrícolas. Porém, estudos recentes revelaram uma alta diversidade de espécies de Metarhizium spp. associadas aos mais diversos habitats, incluindo o solo e a rizosfera de plantas, que é a região onde o solo e as raízes das plantas se encontram, caracterizado por alta atividade microbiana.
Estes achados levaram pesquisadores do mundo todo a uma corrida para caracterizar o estilo de vida “bifuncional” de Metarhizium, levando a descobertas incríveis como seu potencial para ser utilizado como inoculante na promoção de crescimento de plantas, como antagonista de fitopatógenos (patógenos que causam doenças em plantas), como indutor da resistência induzida de plantas, entre outras funções.
Esta nova forma de utilização dos fungos entomopatogênicos na agricultura abre um leque de possibilidades de inclusão destes patógenos, anteriormente empregados apenas para controle de pragas, para aumento nos ganhos de produtividade em campo, aliado à sua clássica utilização de biocontrole, trazendo inúmeros benefícios em um único produto e em uma única aplicação. De lá para cá houve grandes avanços nas pesquisas sobre a utilização destes fungos como promotores de crescimento vegetal, porém ainda era preciso caracterizar muitas coisas, por exemplo, como Metarhizium poderia estar atuando no melhor desenvolvimento das plantas? Quais compostos estariam sendo produzidos por estes fungos, que levariam a maiores ganhos de produção? Como Metarhizium poderia inibir o crescimento de fitopatógenos? Quais espécies de Metarhizium apresentam este potencial?
Para isto, pesquisadores da Escola Superior de Agricultura “Luiz de Queiroz”, a Esalq/USP, do Centro de Energia

Nuclear na Agricultura (Cena/USP) e da Embrapa Meio Ambiente formaram uma equipe multidisciplinar, com o objetivo de desvendar e caracterizar esses novos mecanismos, até então desconhecidos. Os objetivos principais da pesquisa foram compreender os possíveis mecanismos entre isolados brasileiros nativos de Metarhizium envolvidos na promoção de crescimento de plantas e na colonização do sistema radicular utilizando técnicas de microbiologia e plantas de tomate (Solanum lycopersicum L.) da cultivar denominada Micro-Tom.
O trabalho foi publicado no periódico Frontiers in sustainable food systems e está disponível no endereço: https:// www.frontiersin.org/articles/10.3389/ fsufs.2020.00137/full.
Para a execução do trabalho, foram selecionadas três espécies de Metarhizium, depositadas no banco de entomopatógenos da Esalq/USP. As espécies testadas eram todas nativas de diferentes localidades do Brasil, dentre elas, Metarhizium anisopliae, Metarhizium robertsii e uma espécie nova recentemente descrita por pesquisadores brasileiros, Metarhizium humberi. Primeiramente foram conduzidos testes de laboratório para caracterizar a produção de compostos já conhecidos, importantes nos processos de promoção de crescimento e no antagonismo a patógenos de plantas. Ensaios “in vitro” foram conduzidos para verificar a produção do hormônio vegetal

10 dias após a inoculação 30 dias após a inoculação
Tomateiro infectado por PVY com lesões necróticas pequenas na face de cima da folha (esquerda) e na face de baixo da folha (direita)
Depósito do hormônio vegetal auxina nas raízes de tomateiro inoculadas
auxina (Ácido 3-Indol-acético – AIA), responsável por estimular o crescimento de plantas pelas espécies de Metarhizium.
Os resultados indicaram que todas as espécies de Metarhizium mencionadas anteriormente foram capazes de produzir auxina em quantidades significativamente maiores que as produzidas pelo fungo Trichoderma harzianum, utilizado como comparativo, por já ter a produção deste composto confirmada em trabalhos realizados há décadas.
Também foi testada a capacidade de M. anisopliae, M. robertsii e M. humberi em solubilizar fósforo na forma orgânica. Sabe-se que a solubilização de fósforo é

Colonização do sistema radicular através do emprego de técnicas de microbiologia fundamental no crescimento e desenvolvimento das plantas e que, apesar de o solo ser um grande reservatório deste elemento, as plantas só conseguem utilizá-lo na forma inorgânica, necessitando que esta conversão seja feita pela microbiota presente em sua rizosfera. Os testes conduzidos em laboratório utilizaram meios de cultura sólidos contendo diferentes fontes de fósforo, como o fosfato de cálcio (Ca3(PO4)2) e o fitato de cálcio (C6H18O24P6). Todas as espécies avaliadas foram capazes de solubilizar fósforo orgânico, com destaque para M. humberi e M. anisopliae, que apresentaram potenciais maiores que T. harzianum novamente.
Além de compostos importantes para o desenvolvimento de plantas, os pesquisadores avaliaram a capacidade das espécies nativas de Metarhizium em produzir compostos responsáveis pela inibição do crescimento de patógenos de plantas, os fitopatógenos. Os testes conduzidos também em laboratório utilizaram meios de cultura específicos para demonstrar se as espécies testadas seriam capazes de produzir quitinases, componentes importantes na redução de fitopatógenos, de nematoides e, inclusive, de insetos-pragas, e sideró-
Avaliação do crescimento do tomateiro

Dados relativos a flores e frutos

foros, que são compostos quelantes de ferro produzidos por micro-organismos com alta afinidade ao Fe+3 e que são importantes por mediar a aquisição de ferro pelas plantas, composto que está presente no solo, porém não é facilmente adquirido pelas mesmas. Os resultados impressionaram os pesquisadores, visto que ainda não havia relatos da produção de alguns destes compostos por fungos entomopatogênicos do gênero Metarhizium, tampouco tinham sido realizadas pesquisas em território nacional para avaliar tais características. Todas as espécies de Metarhizium testadas produziram grandes quantidades de sideróforos “in vitro” comparado ao controle positivo com T. harzianum e, em menor extensão, também produziram quitinases.
Com os resultados dos testes de laboratório em mãos e, após caracterizar a produção de cada um dos compostos, os pesquisadores partiram para os testes em casa de vegetação “in vivo”, para verificar se os resultados obtidos em laboratório se refletiriam no maior de desenvolvimento e em ganhos de produção de uma importante cultura brasileira, o tomate. Para estes ensaios foi escolhida uma cultivar de tomate mutante, denominada Micro-Tom DR5::GUS, que é um tomateiro anão de rápido crescimento, tendo seu ciclo da semeadura ao amadurecimento dos frutos em até 50 dias, facilitando e agilizando a coleta dos resultados. Além desta característica, o Micro-Tom selecionado para a pesquisa contém em seu material genético um gene “auxina-responsivo”, que quando utilizado em testes bioquímicos, pode revelar a produção do hormônio vegetal auxina por micro-organismos, incluindo os locais onde o AIA está sendo depositado nas plantas que foram inoculadas com estes micro-organismos promotores de crescimento vegetal (MPCV). A produção de auxina e o acúmulo deste hormônio nas raízes do Micro-Tom também foram avaliados e, além disso, os pesquisadores observaram se os fungos seriam capazes de colonizar, ou seja, “penetrar” nos tecidos da planta de tomate.
Os resultados mostraram que a inoculação com os fungos produziu plantas mais altas, raízes mais longas e mais matéria seca da parte aérea e da raiz que os tratamentos sem inoculação fúngica. O número de flores, juntamente com o peso fresco e seco dos frutos, foi significativamente aumentado pela inoculação de M. robertsii e M. humberi em comparação com plantas não inoculadas. M. robertsii e M. humberi também foram capazes de colonizar endofiticamente todos os tecidos do tomate anão e permaneceram nas plantas, mesmo após 30 dias da inoculação das sementes. As plantas inoculadas com
Níveis de produção de auxina

M. robertsii ou M. humberi aumentaram a expressão do promotor “GUS” induzido por auxina nas raízes de Micro-Tom, após a inoculação, confirmando que Metarhizium induziu a expressão gênica deste hormônio nas plantas, culminando no maior enraizamento e, consequentemente, crescimento.
Resumindo, os dados aqui apresentados demonstraram que as espécies nativas M. anisopliae, M. robertsii e M. humberi possuem características interessantes e complementares, como as características bioquímicas, colonização endofítica e estimulação do crescimento vegetal. Juntos, esses achados comprovam os múltiplos benefícios promovidos por Metarhizium quando empregados como bioinoculantes da cultura do tomateiro, podendo ser extrapolados para outras culturas de importância agronômica, para o aumento da produtividade, bem como alívio nos ataques por fitopatógenos, nematoides e insetos-praga.
Os resultados promissores culminaram com a solicitação de registro comercial de um produto baseado nos isolados de M. robertsii e M. humberi e trazem uma perspectiva única sobre a utilização de fungos endofíticos entomopatogênicos como bioestimulantes e biopesticidas. Por fim se faz necessário reiterar que a utilização de fungos entomopatogênicos, principalmente com o objetivo de aproveitar a capacidade endofítica e atuar como colonizadores da rizosfera vegetal, como promotores de crescimento e antagonistas de fitopatógenos, abre mais possibilidades para explorar suas interações com as plantas, o que pode levar ao aumento da produtividade da cultura e a uma menor dependência de insumos químicos. C C
Ana Carolina O. Siqueira, Cassiara Gonçalves, Joelma Marcon, Maria Carolina Quecine e Italo Delalibera Júnior, Esalq/USP Antônio Figueira, Cena/USP Gabriel Moura Mascarin, Embrapa Meio Ambiente Solubilização de fosfatos insolúveis, fitato de cálcio e produção de sideróforos e quitinases


Produção de compostos in vitro
Ana Carolina Oliveira Siqueira










